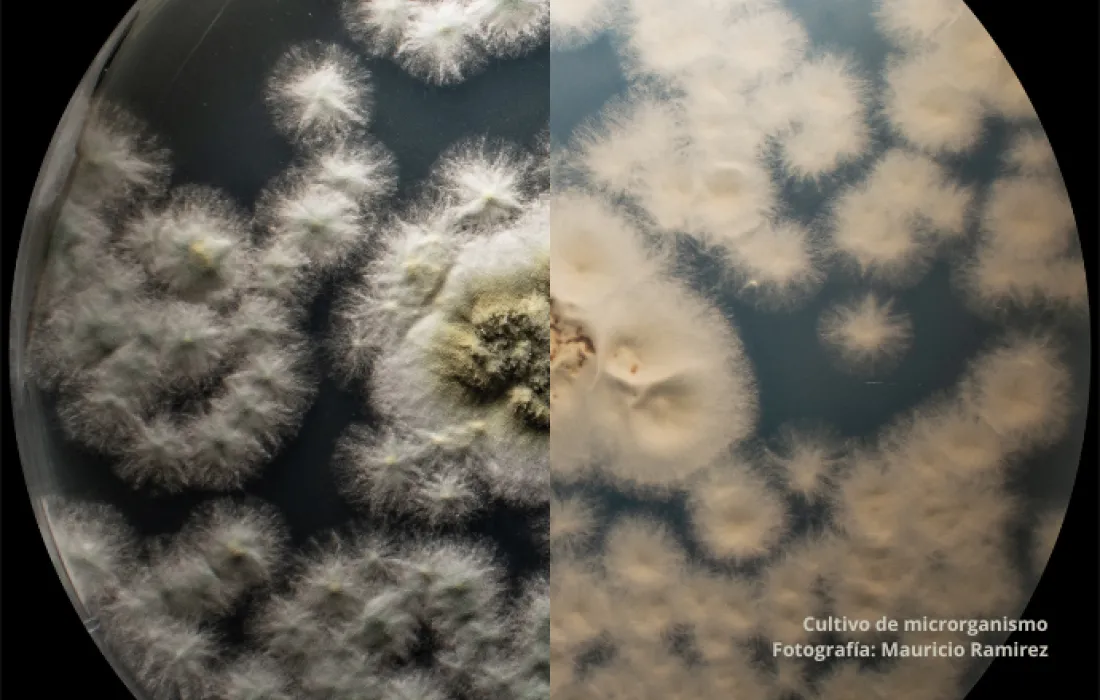

Compostaje de residuos vegetales y residuos crudos de restaurantes




Composteras
Desde abril de 2021, el 100% de los residuos orgánicos generados en la universidad, como hojas, césped y restos de comida de las cafeterías, se gestionan a través de un sistema de compostaje.
Actualmente, se cuenta con 9 composteras, hechas con trincheras de bambú, resultantes de las actividades de poda, para procesar estos residuos y producir fertilizante, que posteriormente es utilizado en el mantenimiento de los jardines.
Durante el 2024 se recolectaron 10.6 toneladas de residuos de jardinería y 11.6 toneladas de residuos de cafeterías, lo que permitió obtener 9.680 kg de compost.
Laboratorio de biofertilizantes
Este laboratorio es el corazón de nuestro esfuerzo por conservar y mejorar las áreas de compostaje. Aquí se abarcan subproyectos dedicados a la preparación y uso de biofertilizantes, el cultivo y aplicación de microorganismos y la vermicultura. Este laboratorio también posee de un área específica para la germinación, siembra, recepción y utilización de nuevos materiales que posteriormente serán trasladados al vivero.
El laboratorio de biofertilizantes desempeña un papel crucial tanto en la conservación como en el fortalecimiento de los sitios de compostaje, dado que aquí se cultivan microorganismos eficientes provenientes del suelo del bosque, los cuales facilitan la maduración del compost. Además, se activan biológicamente sulfatos y rocas fosfóricas que se utilizan en la fertilización foliar de áreas verdes y arbustos, en el control de insectos y enfermedades, reemplazando así el uso de urea, insecticidas y pesticidas.